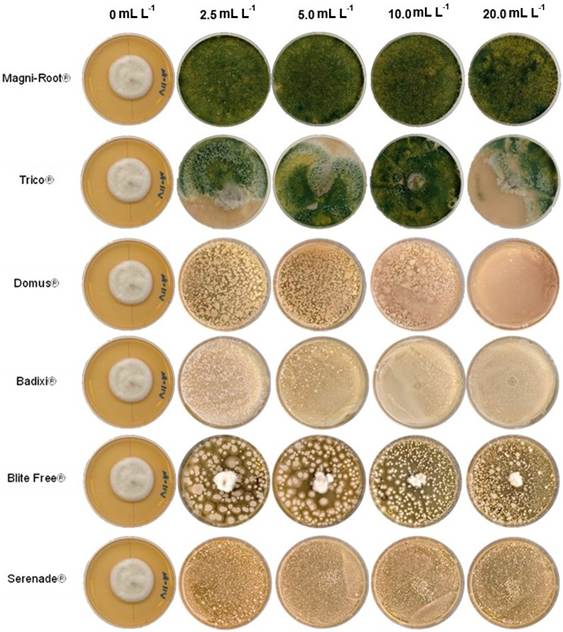

Introducción
En México, el cocotero (Cocos nucifera) es un cultivo cultural y económicamente importante para el estado de Colima, el cual obtuvo el segundo lugar en producción nacional de cocotero con 19, 587.6 ha cosechadas y una producción total de 20,
195.61 t, con un rendimiento de 1.03 t ha -1 (SIAP, 2024). En tanto al ámbito fitosanitario del cocotero, la principal plaga en el pacífico de México es el picudo negro de la palma (Rhynchophorus palmarum), vector principal de Bursaphelenchus cocophilus, agente causal del anillo rojo, y Phytophthora palmivora, causante de la pudrición del cogollo (De la Mora et al., 2022), estas enfermedades pueden ser detectadas en diversos germoplasmas de cocotero, especialmente en los producidos en Colima: “Alto Pacífico” “Ecotipo 4” y “Enano Verde de Brasil” (EVB); sin embargo, no solo nematodos y oomicetos generan afecciones en cocotero, también se pueden encontrar hongos fitopatógenos que pueden inducir diferentes enfermedades (Gemaque et al., 2009).
El híbrido EVB es el germoplasma de cocotero más recientemente cultivado en Colima. Se introdujo en el 2017 y desde entonces, debido a sus características, ha ganado popularidad entre los productores y empresas relacionadas al cocotero en el Valle de Tecomán, al tener una producción precoz a los dos años, ofrecer una productividad de hasta más de 150 drupas por planta y una altura de entre 4 a 6 m, lo cual facilita las labores culturales y la cosecha, en comparación con variedades altas, y principalmente, se utiliza para el consumo de su agua (Benassi et al., 2013). Recientemente, se encontró una sintomatología de fitopatología en el híbrido EVB en un vivero de producción de planta al aire libre en la localidad de Caleras, Tecomán, Colima. La enfermedad corresponde a una mancha foliar (MF), la cual presenta pequeñas manchas ovaladas de apariencia necrótica de color marrón oscuro-rojizo en su inicio y con el tiempo adquieren un matiz marrón claro, con presencia de un anillamiento de tonalidad amarilla (halo) en el borde de estas durante ambas etapas, lo cual coincide con una enfermedad fúngica de acuerdo con los parámetros evaluados por Gemaque et al. (2009).
El principal manejo de las enfermedades fúngicas, incluida la mancha foliar
en palmas de cocotero en vivero, es la aplicación de fungicidas químicos, principalmente con ingredientes activos como benomilo (Benlate), clorotalonil (Daconil) (Palomar y Betonio, 1982), tebuconazole, propiconazole, carbendazin, picoxystrobin, pyraclostrobin, mancozeb, propineb, entre otros (Ushamalini et al., 2019), a pesar de los inconvenientes ambientales que conlleva el uso de estas moléculas y la resistencia que genera en los hongos fitopatógenos.
Una alternativa ecológica que previene la resistencia de los patógenos fúngicos a los fungicidas químicos es el control biológico mediante el uso de biofungicidas a base de microorganismos benéficos, como por ejemplo bacterias y/u hongos filamentosos, que a menudo se encuentran de manera natural en el suelo y controlan hongos y bacterias que causan enfermedades en plantas (Ehiobu et al., 2022). Los biofungicidas actúan por competencia directa (exclusión), antibiosis, parasitismo o depredación, inducción de resistencia a la planta hospedante y promoción del crecimiento vegetal (Fenta y Mekonnen, 2024).
Debido a la introducción de la variedad de cocotero EVB a Colima, se desconocen los patógenos que pueden llegar a ser de importancia económica para este germoplasma. En consecuencia, no se conoce al agente asociado a la MF. Por lo tanto, el objetivo del presente estudio fue caracterizar morfológica, molecular y bioquímicamente al hongo asociado a la MF en palmas de cocotero EVB y evaluar su susceptibilidad a fungicidas biológicos comerciales.
Materiales y Métodos
Origen del material vegetal. En septiembre del 2022 se colectaron al azar hojas con síntomas de MF en palma de cocotero var. EVB en el vivero del rancho “La Ceiba”, en la localidad de Caleras, Tecomán, Colima (18°59’31” N y 103°53’19 O). El clima predominante es cálido subhúmedo (Aw) con lluvias en verano (600 a 1, 100 mm año -1) y 80 msnm. Las hojas se depositaron en bolsas de plástico y en una hielera con geles fríos para su transporte inmediato al laboratorio para el aislamiento del hongo. Al momento del muestreo la incidencia de la enfermedad en palmas del vivero fue del 92.0%.
Aislamiento del agente asociado. Se cortó el área foliar infectada en trozos de 4×4 cm, para su desinfección superficial se realizaron tres lavados de tres minutos cada uno con NaClO al 2.0% + Tween 20® (500 µL L -1), alcohol al 70.0% y agua destilada estéril, después, se eliminó el exceso de humedad con toallas de papel estériles; y se sembraron en cajas de Petri con agar-agua para la proliferación de hifas y estructuras fúngicas. A los siete días, se observaron hifas, conidióforos y conidios, estos fueron purificados a través de punta de hifas en Papa Dextrosa Agar (PDA). Las condiciones de incubación y aislamiento fueron de 25.0±3.0 °C, 75.0±5.0% de humedad relativa (HR) y foto periodo de 14:10 h luz: oscuridad (Conde et al., 2008).
Caracterización morfológica. Bajo condiciones estériles se prepararon cultivos puros del hongo aislado con la metodología del microcultivo de Riddell (1950). Los microcultivos se observaron en microscopio invertido (Axiovert 40 CFL Zeiss, Alemania) con los objetivos 5, 10 y 40×; se tomaron en cuenta características culturales y morfológicas tales como hifas septadas o lisas, aspecto micelial, forma de borde de la colonia, coloración de colonias en medio PDA, ausencia o presencia de conidios, tamaño y forma de los conidios. La descripción de estructuras reproductivas se realizó de acuerdo con Crous et al. (2009), Manamgoda et al. (2014) y Valarmathi y Ladhalakshmi (2018).
Caracterización molecular. Se eligió un aislamiento representativo para la identificación molecular y el ADN genómico se extrajo mediante el protocolo (Miller et al., 1999). Se maceró el tejido fúngico con nitrógeno líquido y se empleó el buffer de lisis (200 mM Tris HC1 pH 7.5, 250 mM NaCl, 25 mM EDTA, 0.5% SDS) para la extracción con fenol-cloroformo. Se amplificó la región D1/D2 de la subunidad 28S ribosomal utilizando los oligonucleótidos NL-1 (5´-GCATATCAATAAGCGGAGGAAAAG-3´) y NL-4 (5´-GGTCCGTGTTTCAAGACGG-3´) (Voigt et al., 1999). Las secuencias se inspeccionaron mediante cromatogramas utilizando el programa SnapGeen Viever™ 7.2.0. La secuencia curada se utilizó para comparar con la base de datos en el GenBank de NCBI utilizando el programa Mega BLAST. Se depositó la secuencia en el GenBank con número de acceso PV034038. Adicionalmente, se descargaron las secuencias más similares relacionadas de Bipolaris en formato FASTA de GenBank (Cuadro 1). Estas secuencias se alinearon usando el algoritmo CLUSTALW con parámetros predeterminados (Thompson et al., 2003) y se editaron manualmente utilizando el paquete de software MEGA 11 (Tamura et al., 2021). Se realizó un análisis filogenético de Máxima Verosimilitud (ML) con el modelo Kimura de 2 parámetros G+I (Kimura, 1980). Los gaps fueron tratados como deleciones parciales con un 95.0% de cobertura, utilizando un método heurístico NNI (intercambio del vecino más cercano, por sus siglas en inglés) para refinar la topología del árbol con 1, 000 réplicas de arranque. Se empleó Fusarium oxysporum como un clado externo.
Cuadro 1 Secuencias utilizadas para la generación del árbol filogenético de Bipolaris oryzae agente asociado a la mancha foliar de cocotero.
| Especie | Número de cepa | Hospedante | País | Gen Bank | Referencia |
|---|---|---|---|---|---|
| Bipolaris incurvata | CBS 127221 | C. nucifera | India | MH875906 | Kamalakannan et al., 2006 |
| Bipolaris oryzae | CBS 127244 | No determinado | Holanda | MH875924 | Vu et al., 2019 |
| B. oryzae | MFLUCC 100715 | Oryza sativa | Thailandia | JX256384 | Manamgoda et al., 2012 |
| B. oryzae | MFLUCC100716 | O. sativa | Thailandia | JX256383 | Manamgoda et al., 2012 |
| B. oryzae | MFLUCC 100733 | O. sativa | Thailandia | JX256385 | Manamgoda et al., 2012 |
| B. oryzae | AR5204 | Panicum virgatum | USA | KM243277 | Manamgoda et al., 2014 |
| B. oryzae | B1 | No determinado | India | OQ349750 | Sin publicar |
| B. oryzae | ACCC 36975 | O. sativa | China | MK051173 | Chaijuckam et al., 2019 |
| B. oryzae | H2-1 | No determinado | Japan | KF590135 | Palomares et al., 2014 |
| Bipolaris secalis | BRIP 14453 | Secale sereale | Argentina | KJ415492 | Tan et al., 2014 |
| B. secalis | UC6 | Vitis vinifera | Italia | KU554624 | Lorenzini et al., 2016 |
| B. secalis | K2d | Sorghum bicolor | Kenya | PP813561 | Sin publicar |
| B. secalis | CBS 127712 | No determinado | Holanda | MH876123 | Vu et al., 2019 |
| Curvularia oryzae | CBS 169.53 | C. nucifera | China | KM243284 | Berbee et al., 1999 |
Caracterización fisiológica y bioquímica. En un experimento se evaluaron cinco medios de cultivo semisólidos: Czapek-Dox (en g L -1: NaCl 0.75, K HPO 0.25, MgSO4 0.125, KCl 0.125, agar bacteriológico 18.0 (Sumathi et al., 2016), glucosa palma de cocotero (en g L -1: glucosa 10 y hojas licuadas palma de cocotero 50), PDA, salvado de trigo-buffer citrato (en g L -1: salvado de trigo 30, NaOH 2.0 y ácido cítrico 9.0 (Sumathi et al., 2016) y Sivakumar (en g L -1: glucosa 20, extracto de levadura 2.5, K2HPO4 1.0, MgSO4 0.5, KCl 0.5, (NH4)2SO4 0.5, CaCl2 0.01,
FeSO4 0.01, MnSO4 0.001, ZnSO4 0.001 y CuSO4 0.002 (Sivakumar et al., 2010).
Los medios de cultivo se prepararon, esterilizaron y vertieron en cajas de Petri de 100×15 mm. Como inóculo, se colocó un disco de micelio desarrollado en agar de una colonia de Bipolaris oryzae de 12 días de edad en jugo V8-agar en el centro de la caja de Petri. Se empleó un diseño completamente al azar.
La caracterización fisiológica se realizó cuantificando la tasa de crecimiento diaria (TCD) y esporulación. La TCD se determinó midiendo el diámetro de las colonias de B. oryzae durante cinco días. La TCD se calculó con la fórmula:
dónde, n = fue el número de evaluaciones y Ct = el número de días de crecimiento. Para la esporulación, en tubos Falcon® (50 mL) con 10 mL de agua destilada estéril con Tween 80® (0.005%) se depositaron 10 discos de micelio agar de siete días de edad, provenientes de los medios de cultivo evaluados, los tubos se agitaron en vórtex por 60 s, se tomaron 10 µL y se contabilizó el número de conidios disco -1 mL -1 en una cámara de Neubauer en microscopio (Axio Vert A1, Zeiss, Alemania) con un objetivo de 40× (Manzo-Sánchez et al., 2018).
La caracterización bioquímica de B. oryzae incluyó la producción de lacasa (volumétrica y específica) y proteína total. A partir de discos de micelio agar obtenidos del conteo de esporulación, las muestras se filtraron con papel filtró estéril (Whatman No 1) para evitar conidios y micelio. Con el filtrado se determinó la actividad lacasa por el método de oxidación del ABTS (2,2’-azinobis [3-etilbenzotiazolina-6-ácido sulfónico]-sal de diamonio) (Chan et al., 2019) y el contenido de proteína total por el método de Bradford (Kielkopf et al., 2020). La actividad lacasa se reportó en U (unidad internacional: cantidad de la lacasa que oxidó 1 μmol de ABTS mL -1 min -1) y la proteína en mg L -1.
Sensibilidad a fungicidas biológicos a base de microorganismos. Para los bioensayos se evaluaron: Serenade ASO® (Bacillus subtilis, Bayer®), Badixi® (Bacillus amyloliquefaciens cepa MBI 600, Syngenta®), Magni-Root® (Trichoderma harzianum, PlantBio®), Trico® (Trichoderma viride, Greenfor®), Blite Free® (Streptomyces jofer, enriquecido con antioxidantes, medio de cultivo y agentes quelantes, AltusBio®) y Domus® (B. subtilis, T. harzianum y Streptomyces lydicus, CollectTara®). La selección de los productos se realizó en función de su disponibilidad en las casas agrícolas de Tecomán, Colima. Los productos biológicos fueron evaluados en dosis (concentración %) de 2.5 (0.25%), 5.0 (0.5%), 10 (1.0%) y 20 mL L -1 (2.0%), las dosis (mL L -1) se prepararon en agua destilada estéril (100 mL) + Tween 80® (0.05%); con una micropipeta se tomaron 1, 000 µL y se depositaron sobre la superficie del medio PDA solidificado en cajas de Petri de 100×15 mm; se realizaron cinco repeticiones por cada dosis evaluada en cada producto. La siembra del hongo fitopatógeno se realizó depositando en el centro de la caja de Petri cinco µL de una solución de esporas a una concentración de
9.2×104 esporas mL -1. Las cajas de Petri inoculadas se incubaron bajo condiciones
de laboratorio a una temperatura de 25.0 ± 3.0 °C. 75 ± 5.0% de HR: 10:14 h luz: oscuridad durante cinco días (Chan et al., 2014). Se determinó el porcentaje de inhibición del crecimiento micelial (%ICM) con la siguiente ecuación: %ICM = [(C - T) / C] * 100, donde C es el diámetro del micelio en la caja Petri control (mm), y T es el diámetro del micelio en las cajas de tratamiento con fungicidas biológicos (mm). También se determinó la dosis letal noventa DL90, que hace referencia a la cantidad de fungicida biológico necesario para inhibir el desarrollo del fitopatógeno en un 90%, se estimó empleando los valores del %ICM en cada dosis evaluada de cada producto. Esta estimación se realizó mediante un análisis Probit (Manzo- Sánchez et al., 2018) utilizando el software Statistical Analysis System (SAS) ver. 8 para Windows (SAS Insti-tute Inc., 2000).
Análisis de datos. Los datos de caracterización fisiológica y bioquímica (TCD, esporulación, actividad lacasa y producción de proteína total) y efectividad in vitro (%ICM) se sometieron a un análisis de homogeneidad de varianzas (P < 0.05) y análisis de varianza (P < 0.05). Se encontraron diferencias significativas, se realizó una comparación de medias Tukey con un nivel de significancia al 5%. Además, se realizó un análisis de regresión lineal (Y=mX+b) entre las dosis empleadas de los productos a evaluar (X) y los porcentajes de inhibición (Y), para conocer su relación. Los análisis se realizaron con el software StatGraphics Plus 4.0 para Windows (Manzo-Sánchez et al., 2018).
Resultados
Caracterización morfológica y molecular. Los síntomas de la MF encontrada en plantas de coco EVB corresponden a pequeñas manchas ovaladas de color negro y marrón, las manchas crecen paulatinamente a través de un halo ligeramente amarillo, ocasionando un debilitamiento y amarillamiento generalizado de las hojas, posteriormente ocasiona la muerte de esta (Figura 1). Las principales características culturales y morfológicas del hongo se muestran en la Figura 2. Macroscópicamente el micelio fue de color blanco en sus primeros siete días de crecimiento, tornándose a una tonalidad marrón-grisáceo conforme el micelio madura al formar los conidióforos y conidios a los 12 días de edad (Figura 2I y 2J). Microscópicamente las hifas fueron septadas, color marrón claro (Figura 2A, 2B y 2H), conidios rectos (Figura 2C, 2D, 2E y 2F), distoseptados (5 - 6 septos), de color marrón, de forma elipsoidal y estrechándose hacia sus extremos en forma redondeada. Los conidióforos son septados y agrupan entre 2 a 8 conidios (Figura 2G), con un promedio de 4.0±1.4 µm (media ± desviación estándar (DE), asimismo las hifas también son septadas (Figura 2H). El largo de los conidióforos fue de 114.8±34.1 µm (media ±DE n=100) y las dimensiones de los conidios fueron de 16.1±1.5 µm x 5.2±0.4 µm (media ±DE n=100). Los aislamientos se identificaron como Bipolaris oryzae según sus características morfológicas (Manamgoda et al. 2014; Meghana y Hiremath 2019; Livitha y Christopher 2023).
Para confirmar la identificación morfológica del agente asociado a la MF, se eligió un aislamiento representativo para la identificación molecular y el ADN genómico se extrajo mediante el protocolo Miller et al., (1999). Se secuencio la región D1/D2 del amplicón de la subunidad mayor 28S del ARN ribosomal (Voigt et al., 1999). Las secuencias del aislamiento representativo (ACMFCnhEVB_1) se depositaron en el GenBank (PV034038). El análisis de BLAST de las secuencias parciales mostró un 98.27% de similitud con los aislados de Bipolaris oryzae (GenBank OQ349750.1). Para comparar el asilado de B. oryzae (agente asociado MFCnhHVB) reportado en este trabajo con otras cepas de Bipolaris spp., se realizó un análisis filogenético con secuencias de distintas cepas y especies relacionadas utilizando los softwares ClustalW y MEGA11 con el método Máxima Verosimilitud (Figura 3). El análisis se realizó con un total de 14 secuencias de Bipolaris spp., nueve reportadas como patógenas (una de B. incurvata y ocho de B. oryzae), cuatro de B. secalis utilizado como clado hermano, y dos secuencias correspondientes a
B. incurvata y Curvularia oryzae (Berbee et al., 1999; Kamalakannan et al., 2006) reportados como patógeno de C. nucifera (Cuadro 1). El aislado MFCnhHVB reportado en este trabajo se agrupó en el Clado de Bipolaris oryzae cepa B1 (OQ349750.1) y H2-1 (KF590135.1). Con base en los datos de secuencia y el análisis filogenético, el hongo aislado de cocotero de MF fue identificado como B. oryzae (Figura 3).

Figura 1 Hojas con síntomas de mancha foliar en palma de cocotero híbrido “Enano Verde de Brasil”. A) Manchas ovaladas color marrón y halo amarillo, B) hojas con de palma con múltiples manchas ovaladas y C) vista del vivero con plantas con síntomas de mancha foliar.

Figura 2 Características culturales y morfológicas de Bipolaris oryzae. A y B) Conidioforos; C a F) conidiosporas; G) agrupación de conidióforos; H) hifas septadas; I) micelio joven de cinco días de crecimiento en medio; J) micelio maduro de 20 días de crecimiento en medio PDA.

Figura 3 Análisis filogenético con base en el método de máxima verosimilitud utilizando el modelo Kimura de 2 parámetro (G+I). Árbol creado con el logaritmo de probabilidad más alto (-5759.36) de la secuencia del ADNr 28S de las cepas de Bipolaris similares a las del agente asociado a la MF en palma de cocotero EVB (Bipolaris oryzae ACMFCnhEVB_1) usando MEGA11. Es árbol se enraizó utilizando a Fusarium oxysporum se utilizó como grupo externo.
Caracterización bioquímica y fisiológica. B. oryzae produjo lacasa volumétrica en un rango de 0.66 a 15.34 U L -1 en los medios de cultivo evaluados (Cuadro 2). La mayor actividad (P=0.00001) se encontró en el medio Sivakumar (15.34 U L -1), seguido del ST (8.5 U L -1). Para la producción de proteína total por B. oryzae, no se encontraron diferencias significativas (P=0.6478) entre los medios de cultivo evaluados. El rango de proteína encontrada fue de 0.40 a 0.78 mg L -1 (Cuadro 2). La actividad lacasa específica fue estadísticamente mayor (P=0.0005) en los medios de cultivo Sivakumar (25.54 U mg de proteína -1) y ST (22.17 U mg de proteína -1). La TCD osciló entre 0.87 y 1.7 cm día -1, los medios Czapek-Dox (1.75 cm día -1) y GAC (1.67 cm día -1) permitieron una mayor TCD a comparación del PDA (0.87 cm día -1). El medio ST permitió una mayor esporulación de B. oryzae (329 conidio mL -1 disco -1) (P=0.00001), en comparación con los medios Czapek- Dox, GAC y Sivakumar que presentaron 42.0, 31.0, 37.0 conidios mL -1 disco -1, respectivamente (Cuadro 2).
Cuadro 2 Actividad lacasa, tasa de crecimiento diario (TCD) y esporulación de Bipolaris oryzae en medios semisólidos.
| Medio de Cultivo | Actividad volumétrica (U L-1) | Contenido de proteína (mg L-1) | Actividad específica (U mg de proteína-1) | TCD (cm día-1) | Esporulación (conidiosporas mL-1 disco-1) |
|---|---|---|---|---|---|
| Cz-D | 2.42±1.51 c | 0.72±0.14 | 3.38±2.37 b | 1.75±0.23 a | 42.0±7.3 b |
| GAC | 0.66±0.12 c | 0.69±0.19 | 1.44±0.60 b | 1.67±0.17 a | 31.0±5.7 b |
| APD | 2.87±0.15 c | 0.70±0.23 | 5.03±0.97 b | 0.87±0.18 b | - |
| ST | 8.5±0.64 b | 0.40±0.04 | 22.17±3.15 a | 1.32±0.02 ab | 329.0±36.5 a |
| Sivakumar | 15.34±2.19 a | 0.78±0.24 | 25.54±7.19 a | 1.2±0.13 ab | 37.0±5.8 b |
| F= | 23.93 | 0.63 | 9.46 | 4.66 | 63.37 |
| P= | 0.00001 | 0.6478 | 0.0005 | 0.0121 | 0.00001 |
Medias (± error estándar) con diferente literal son estadísticamente diferentes entre sí, de acuerdo con la comparación de medias Tukey (P=0.05). Cz-D=czapek-Dox, GAC=glucosa agua de coco, PDA=papa dextrosa agar, ST=salvado de trigo.
Efectividad in vitro de fungicidas biológicos. El biofungicida Magni-Root® (T. harzianum) inhibió al 100% el crecimiento micelial de B. oryzae en las cuatro dosis evaluadas (Cuadro 3, Figura 4). Trico® (T. viride) causó una inhibición del 100% de B. oryzae en el primer muestreo; sin embargo, a partir del segundo día, el porcentaje disminuyó hasta valores de 4.1±2.6 y 0.4±0.2 % a una dosis de 20 mL L -1 y 10 mL L -1, respectivamente. Al final de la evaluación (5 días de interacción), los porcentajes oscilaron entre 43.2 y 55.2%, a una dosis de 2.5 y 20 mL L -1, respectivamente. Domus® (B. subtilis, T. harzianum y S. lydicus) ocasionó inhibiciones del crecimiento de B. oryzae del 100%; con la dosis del 20 mL L -1 durante los cinco días de evaluación, mientras que la dosis de 10 mL L -1 mantuvo inhibiciones del crecimiento de 85.9, 89.7 y de 91.9% a los tres, cuatro y cinco días de evaluación, respectivamente. Badixi® (B. amyloliquefaciens) y Serenade ASO® (B. subtilis) inhibieron el crecimiento de B. oryzae al 100% en las dosis de 20, 10 y 2.5 mL L -1 a los cinco días de evaluación. La dosis de 5.0 mL L -1 obtuvo la menor inhibición con los productos Badixi®=90.7% y Serenade ASO®=94.2%. BliteFree® (Streptomyces jofer) presentó 100% de inhibición contra B. oryzae en las cuatro dosis evaluadas, pero al segundo día, este porcentaje bajó a valores entre 18.2 y 1.8%. Conforme avanzó el experimento, la inhibición del crecimiento mostró un aumento, y para el día cuatro de estudio, el %ICM no presentó diferencias significativas entre las dosis estudiadas, inhibiendo al hongo hasta un 69% (Cuadro 3, Figura 4).
Cuadro 3 Inhibición del crecimiento micelial (%) de Bipolaris oryzae por diferentes dosis de fungicidas biológicos comerciales.
| Producto | Dosis (mL L-1) | Días de evaluación | ||||
|---|---|---|---|---|---|---|
| 1 | 2 | 3 | 4 | 5 | ||
| 20 | 100.0±0.0 a | 100.0±0.0 a | 100.0±0.0 a | 100.0±0.0 a | 100.0±0.0 a | |
| 10 | 100.0±0.0 a | 100.0±0.0 a | 100.0±0.0 a | 100.0±0.0 a | 100.0±0.0 a | |
| Magni-Root® | 5 | 100.0±0.0 a | 100.0±0.0 a | 100.0±0.0 a | 100.0±0.0 a | 100.0±0.0 a |
| 2.5 | 100.0±0.0 a | 100.0±0.0 a | 100.0±0.0 a | 100.0±0.0 a | 100.0±0.0 a | |
| F | NC | NC | NC | NC | NC | |
| P-valor | NC | NC | NC | NC | NC | |
| Producto | Dosis (mL L-1) | Días de evaluación | ||||
| 1 | 2 | 3 | 4 | 5 | ||
| 20 | 100.0±0.0 a | 4.1±2.6 a | 24.8±4.8 ab | 44.1±4.1 a | 55.2±3.7 a | |
| 10 | 100.0±0.0 a | 0.4±0.2 a | 28.8±5.9 a | 47.5±4.1 a | 58.3±3.0 a | |
| Trico® | 5 | 100.0±0.0 a | 1.4±1.4 a | 6.6±6.6 b | 17.4±8.9 b | 35.6±7.3 b |
| 2.5 | 100.0±0.0 a | 0.0±0.0 a | 9.5±2.6 ab | 29.6±4.8 ab | 43.2±4.3 ab | |
| F | NC | 1.59 | 4.46 | 5.67 | 4.71 | |
| P-valor | NC | 0.2225 | 0.0148 | 0.0056 | 0.0121 | |
| Producto | Dosis (mL L-1) | Días de evaluación | ||||
| 1 | 2 | 3 | 4 | 5 | ||
| 20 | 100.0±0.0 a | 100.0±0.0 a | 100.0±0.0 a | 100.0±0.0 a | 100.0±0.0 a | |
| 10 | 100.0±0.0 a | 75.3±11.6 ab | 85.9±6.3 ab | 89.7±4.8 ab | 91.9±3.8 ab | |
| Domus® | 5 | 100.0±0.0 a | 50.6±12.0 b | 71.8±6.9 b | 79.4±5.0 b | 83.8±4.0 b |
| 2.5 | 100.0±0.0 a | 42.3±8.4 b | 67.1±4.8 b | 75.9±3.5 b | 81.1±2.8 b | |
| F | NC | 7.69 | 7.69 | 7.69 | 7.69 | |
| P-valor | NC | 0.0013 | 0.0013 | 0.0013 | 0.0013 | |
| Producto | Dosis (mL L-1) | Días de evaluación | ||||
| 1 | 2 | 3 | 4 | 5 | ||
| 20 | 100.0±0.0 a | 100.0±0.0 a | 100.0±0.0 a | 100.0±0.0 a | 100.0±0.0 a | |
| 10 | 100.0±0.0 a | 100.0±0.0 a | 100.0±0.0 a | 100.0±0.0 a | 100.0±0.0 a | |
| Badixi® | 5 | 100.0±0.0 a | 83.5±11.0 a | 83.9±5.7 b | 88.2±4.1 b | 90.7±3.3 b |
| 2.5 | 100.0±0.0 a | 100.0±0.0 a | 100.0±0.0 a | 100.0±0.0 a | 100.0±0.0 a | |
| F | NC | 2.23 | 8.00 | 8.00 | 8.00 | |
| P-valor | NC | 0.1165 | 0.0011 | 0.0011 | 0.0011 | |
| Producto | Dosis (mL L-1) | Días de evaluación | ||||
| 1 | 2 | 3 | 4 | 5 | ||
| 20 | 100.0±0.0 a | 18.2±10.9 a | 47.0±8.3 a | 61.0±6.1 a | 69.1±4.8 a | |
| 10 | 100.0±0.0 a | 1.8±1.3 a | 35.6±3.1 a | 52.2±2.4 a | 61.8±2.0 a | |
| BliteFree® | 5 | 100.0±0.0 a | 7.8±4.6 a | 42.9±5.4 a | 58.3±4.0 a | 67.2±3.1 a |
| 2.5 | 100.0±0.0 a | 9.8±7.2 a | 38.2±4.4 a | 53.2±3.7 a | 61.8±3.7 a | |
| F | NC | 0.95 | 0.80 | 0.97 | 1.12 | |
| P-valor | NC | 0.4336 | 0.5062 | 0.4248 | 0.3657 | |
| Producto | Dosis (mL L-1) | Días de evaluación | ||||
| 1 | 2 | 3 | 4 | 5 | ||
| 20 | 100.0±0.0 a | 100.0±0.0 a | 100.0±0.0 a | 100.0±0.0 a | 100.0±0.0 a | |
| 10 | 100.0±0.0 a | 100.0±0.0 a | 100.0±0.0 a | 100.0±0.0 a | 100.0±0.0 a | |
| Serenade ASO® | 5 | 100.0±0.0 a | 100.0±0.0 a | 89.9±4.5 b | 92.6±3.3 b | 94.2±2.6 b |
| 2.5 | 100.0±0.0 a | 100.0±0.0 a | 100.0±0.0 a | 100.0±0.0 a | 100.0±0.0 a | |
| F | NC | NC | 5.00 | 5.00 | 5.00 | |
| P-valor | NC | NC | 0.0095 | 0.0095 | 0.0095 | |
Medias (± error estándar) con diferente literal son significativamente diferentes entre sí, de acuerdo con la comparación de medias Tukey α=0.05. NC=No calculado por el software. n= 6 se refiere a las repeticiones por dosis.
Figura 4 Crecimiento de Bipolaris oryzae a cinco días después de la inoculación en PDA modificado con diferentes dosis de fungicidas biológicos comerciales.
Para la DL90 en Magni-Root® (T. harzianum) no pudo ser calculada porque inhibió al 100% el crecimiento micelial de B. oryzae en las cuatro dosis evaluadas (Cuadro 4). Tanto Badixi® (Bacillus amyloliquefaciens) y Serenade ASO® (Bacillus subtilis), arrojaron valores negativos; sin embargo, mostraron %ICM contra B. oryzae de 83.9 al 100% (Cuadro 3). Domus® (B. subtilis, T. harzianum y S. lydicus) presentó el valor más bajo con una DL de 7.52 mL L -1, siendo
8.64 y 16.26 veces menor respecto a Trico® (Trichoderma viride) y Blite Free® (Streptomyces jofer) (Cuadro 4).
Cuadro 4 Dosis letal noventa (DL90) de seis fungicidas biológicos comerciales sobre Bipolaris oryzae.
| Producto | DL90 (mL L-1) | IC (mL L-1) | Pendiente | Ecuación probit | χ2 | P>χ2 |
|---|---|---|---|---|---|---|
| Magni-Root® | NC | NC | NC | NC | NC | NC |
| Trico® | 65.04 | 51.5 – 91-0 | 0.0238 | Y= 0.0238X + (-0.2699) | 42.5682 | 0.00005 |
| Domus® | 7.52 | 6.7 – 8.4 | 0.0956 | Y= 0.0956X + 0.5618 | 9.6654 | 0.00790 |
| Badixi® | -2.89 | -8.90 – -0.14 | 0.0717 | Y= 0.0717X + 1.4891 | 114.8000 | 0.00000 |
| BliteFree® | 122.31 | 66.2 – 5242.4 | 0.0079 | Y= 0.0079X + 0.3127 | 6.6607 | 0.03570 |
| Serenade ASO® | -6.45 | -19.30 – -2.12 | 0.0667 | Y= 0.0667X + 1.7129 | 71.8874 | 0.00002 |
DL90= Dosis letal noventa, IC= intervalo de confianza, NC= No calculado por el software.
En la Figura 5 se muestra el análisis de regresión efectuado a cada fungicida biológico, en relación con el porcentaje de inhibición y dosis utilizada. Magni- Root® (T. harzianum) presentó la mayor relación entre las variables ensayadas (R2=1.00) en comparación con los demás productos evaluados, cuyos coeficientes de regresión (R2) oscilaron entre 0.05 - 0.5. Estos resultados indican una relación baja entre las mismas en los otros productos.
Discusión
El género Bipolaris posee especies versátiles ecológicamente, es decir, son de hábito saprobio, endófito y parásito (Kuan et al., 2015; Bengyella et al., 2019). El hábito saprobio se debe a su habilidad heterotálica para prosperar en el suelo y en restos vegetales (Sun et al., 2020). Su hábito endofítico se explica por su capacidad para colonizar hojas, tallos y raíces de plantas sin activar sus genes de patogenicidad, además de producir metabolitos secundarios con importantes funciones biológicas, como contribuir a la asociación con el hospedante (Schulz et al., 2002). Esta habilidad endofítica le permite producir sustancia de interés biotecnológico por ejemplo ácidos orgánicos, enzimas y sideróforos (Bengyella et al., 2019). En cuanto a su hábito parásito, se debe a su capacidad para parasitar plantas; la mayoría de las 100 especies descritas de Bipolaris (Manamgoda et al., 2014; Bengyella et al., 2019) son patógenos vegetales las cuales están asociadas a mancha foliar, pudrición de raíz, pudrición de plántulas y otras enfermedades en gramíneas, plantas silvestres e incluso árboles frutales. B. oryzae, B. maydis y B. sorokiniana son consideradas las especies más devastadoras del género (Sun et al., 2020; Khan et al., 2023).
Las especies de Bipolaris, han sido reportadas como patógenos de diversos
géneros de palmas (Dypsis, Phoenix, Cocos, Adonia, Caryota, Elaeis, entre otras) causando mancha foliar. En C. nucifera se han reportado únicamente las especies Bipolaris incurvata (Antes Helminthosporium incurvatum) (Elliott et al., 2004) en Hawái e India (Kamalakannan et al., 2006); Bipolaris setariae (Niu et al., 2014) en China y Bipolaris sp. en Ghana (Lekete et al., 2022), por lo tanto, este es el primer reporte de B. oryzae como agente asociado a la mancha foliar en C. nucifera en México y el mundo.
Por otra parte, las lacasas (EC. 1.10.3.2) son enzimas oxidorreductasas que contienen cobre y catalizan la oxidación de un solo electrón en una amplia gama de sustratos orgánicos, como carbohidratos, compuestos aromáticos, no aromáticos, fenólicos y no fenólicos que implican la reducción de oxígeno a agua. La lacasa es una enzima importante en la degradación de lignina en la naturaleza y es sintetizada mayormente por hongos Basidiomycetos y Ascomycetos (Chan et al., 2019). Los hongos fitopatógenos pueden producir varias isoenzimas de lacasa codificadas por múltiples genes. Al menos se han identificado alrededor de 10 funciones de genes de lacasa en hongos fitopatógenos (Wei et al., 2017). B. oryzae fue capaz de producir lacasas en todos los medios de cultivo evaluados, incluso en PDA, pero su mayor actividad se encontró en el medio Sivakumar; esto se podría deber a que el medio posee mejor contenido nutrimental, especialmente CuSO4 (0.002 g/L), inductor de la lacasa multicobre (Chan-Cupul et al., 2019).
Únicamente se ha reportado la habilidad de B. maydis para la producción de lacasa (Joseph et al., 2019), por lo tanto, el presente trabajo representa un aporte nuevo a la fisiología de B. oryzae en cuanto a la producción de lacasa, enzima relacionada a la patogénesis, esporulación y melanización micelial en el género Bipolaris (Kandan et al., 2013; Lü et al., 2017; Wei et al., 2017). Las lacasas fúngicas, incluidas las producidas por B. oryzae, son enzimas versátiles con gran importancia en la agricultura y en diversas industrias. Estas oxidasas que contienen cobre desempeñan un papel crucial en la síntesis de lignina, la degradación y el mantenimiento de la salud del suelo (Zhai et al., 2024). Las lacasas pueden oxidar una amplia gama de compuestos fenólicos y no fenólicos, lo que las hace valiosas para aplicaciones como el procesamiento de alimentos, la biorremediación y las industrias textiles (Upadhyay et al., 2016).
Por otra parte, en el género Bipolaris la esporulación es una etapa fisiológica importante; los conidios son más infectivos en plantas que el propio micelio (Hau y Rush, 1980), por lo tanto, conocer la tasa de crecimiento y esporulación de B. oryzae en diferentes medios de cultivo es una actividad preponderante en el estudio de la patogénesis del hongo en su hospedante. La esporulación de B. oryzae fue mayor en el medio salvado de trigo, un medio básico y económico; esto coincide con lo reportado por Hau y Rush (1980) al emplear agar con polvo de arroz (15 g L -1), el cual produjo en promedio 8.7×107 conidios por caja de Petri (100×15 mm). En cuanto a la TCD, los medios de cultivo glucosa palma de coco y Czapek-Dox permitieron la mayor velocidad de crecimiento; esto podría deberse al extracto de palma de coco el cual emula al sustrato natural del fitopatógeno; mientras que al Czapek-Dox podría favorecerle la cantidad de sales (NaCl, MgSO4, KCl, K2HPO4) que contiene, ya que este medio ha sido empleado previamente para el crecimiento de B. oryzae (Hau y Rush, 1980). Otros medios reportados para el crecimiento de B. oryzae son extracto de malta agar, almidón agar, harina de maíz agar, hoja de arroz agar y polvo de arroz agar (Arshad et al., 2013; Thakur et al., 2023).
Los bioensayos in vitro revelaron la efectividad de T. harzianum para suprimir el
crecimiento in vitro de B. oryzae al 100% en las cuatro concentraciones evaluadas. En contraste, T. viride solo fue capaz de inhibir a B. oryzae hasta un 58.3%. Es ampliamente conocido la habilidad de T. harzianum para el control biológico de hongos fitopatógenos, incluido B. oryzae, al respecto Pérez et al. (2013) y Pérez et al. (2018), reportaron la efectividad de T. harzianum sobre B. oryzae, agente causal de la mancha parda en plantas de arroz (Oryza sativa L.), al inhibir el crecimiento in vitro en 64.4% y reducir la enfermedad hasta 93.1% en evaluaciones in vivo. Sin embargo, no todas las cepas de Trichoderma resultan ser efectivas, al respecto Bedoya et al. (2021), reportaron porcentajes bajos de inhibición micelial en B. oryzae por Trichoderma spp., entre 6.1 y 27.5%. El principal mecanismo de supresión de B. oryzae por T. harzianum es el micoparasitismo (Abdel et al., 2007). En las interacciones duales se observa como T. harzianum puede crecer, desplazar y parasitar a B. oryzae. Sin embargo, no se descarta la posibilidad de otros mecanismos de acción como la producción de metabolitos y enzimas que afecten la pared celular de B. oryzae (Khan et al., 2020).
Los productos a base de bacterias (Serenade ASO®, Badixi®, Domu® y BliteFree®) resultaron efectivos para inhibir el crecimiento micelial de B. oryzae. Al respecto,Zárate et al. (2022) sugieren que el control biológico con B. subtilis (Serenade ASO®) puede resultar mejor que el control químico, al reportar inhibiciones miceliales en Bipolaris cynodontis entre 94.7 a 100% bajo condiciones in vitro, valores similares a los encontrados en este estudio con B. oryzae (94.2- 100% de IMC). En otro estudio, Chiangsin et al. (2018), reportaron una inhibición micelial in vitro de 73.5% en B. oryzae por efecto de B. subtilis, mientras que, Karan et al. (2022), reportaron inhibiciones in vitro entre 31.1 y 70.0% con diversas cepas de B. subtilis. Asimismo, B. amyloliquefaciens se ha identificado como agente de biocontrol contra B. oryzae al reducir su crecimiento micelial in vitro hasta 78.6% y reducir la incidencia de la enfermedad en plantas de arroz en 72.6% (Prabhukarthikeyan et al., 2019).
Las actinobacterias, entre ellas Streptomyces, son capaces de inhibir el crecimiento de fitopatógenos de importancia económica (Sánchez et al., 2022). Para B. oryzae se han reportado inhibiciones menores al 50% y una concentración mínima inhibitoria de 1.25 mg mL -1 de filtrado de Streptomyces sp. cepa G, aislado de suelos iraníes (Nejad et al., 2014). En otro estudio, Fathi et al. (2019), reportaron la habilidad in vitro de diversas cepas de Streptomyces para inhibir el crecimiento micelial de B. oryzae, las inhibiciones más altas fueron del 50.0%. Este valor fue superado por el porcentaje de inhibición micelial que mostró S. lydicus (Domus®, 81.1-100%) y S. jofer (BlireFree®, 69.1%), empleados en este estudio. En B. maydis se han reportado porcentajes de inhibición micelial del 80.0% por efecto de lactonas producidas por Streptomyces sp. SN5431 en experimentos in vitro (Wang et al., 2023), este porcentaje fue similar al encontrado en este estudio con S. lydicus (Domus®, 81.1-100%) y S. jofer (BlireFree®, 69.1%).
El presente trabajo aporta al conocimiento fitopatológico del cultivo de cocotero, específicamente del híbrido EVB, recientemente introducido en el pacífico de México. Se reporta por primera vez a Bipolaris oryzae como el agente asociado a la mancha foliar del cocotero, y se propone el uso de agentes de control biológico a base de T. harzianum, T. viride, B. subtilis, B. amyloliquefaciens, S. lydicus, S. jofer. Sin embargo, es fundamental realizar estudios bajo condiciones de campo (in situ) o vivero para entender la epidemiología de la enfermedad bajo aplicaciones de los fungicidas biológicos comerciales más efectivos en este estudio.
Conclusiones
De acuerdo con la caracterización morfológica e identificación molecular, se confirmó que Bipolaris oryzae es el agente asociado a la mancha foliar en palma de cocotero híbrido “Enano Verde de Brasil”. B. oryzae es capaz de producir lacasa, una enzima implicada en la patogénesis. Los medios de cultivo Sivakumar y salvado de trigo fueron los que permitieron mayor actividad lacasa de B. oryzae. Además, el medio salvado de trigo permitió la mayor esporulación (329.0 conidiosporas/mL/ disco) y adecuada tasa de crecimiento diaria (1.32 cm día -1). En los bioensayos con fungicidas biológicos comerciales, T. harzianum destacó sobre T. viride al inhibir en 100% el crecimiento de B. oryzae en las cuatro dosis evaluadas. Las bacterias B. subtilis (100%), S. lydicus (100%) y B. amyloliquefaciens (100%) fueron más efectivas en el control in vitro de B. oryzae comparado con la actinobacteria S. jofer (69.1%).
















